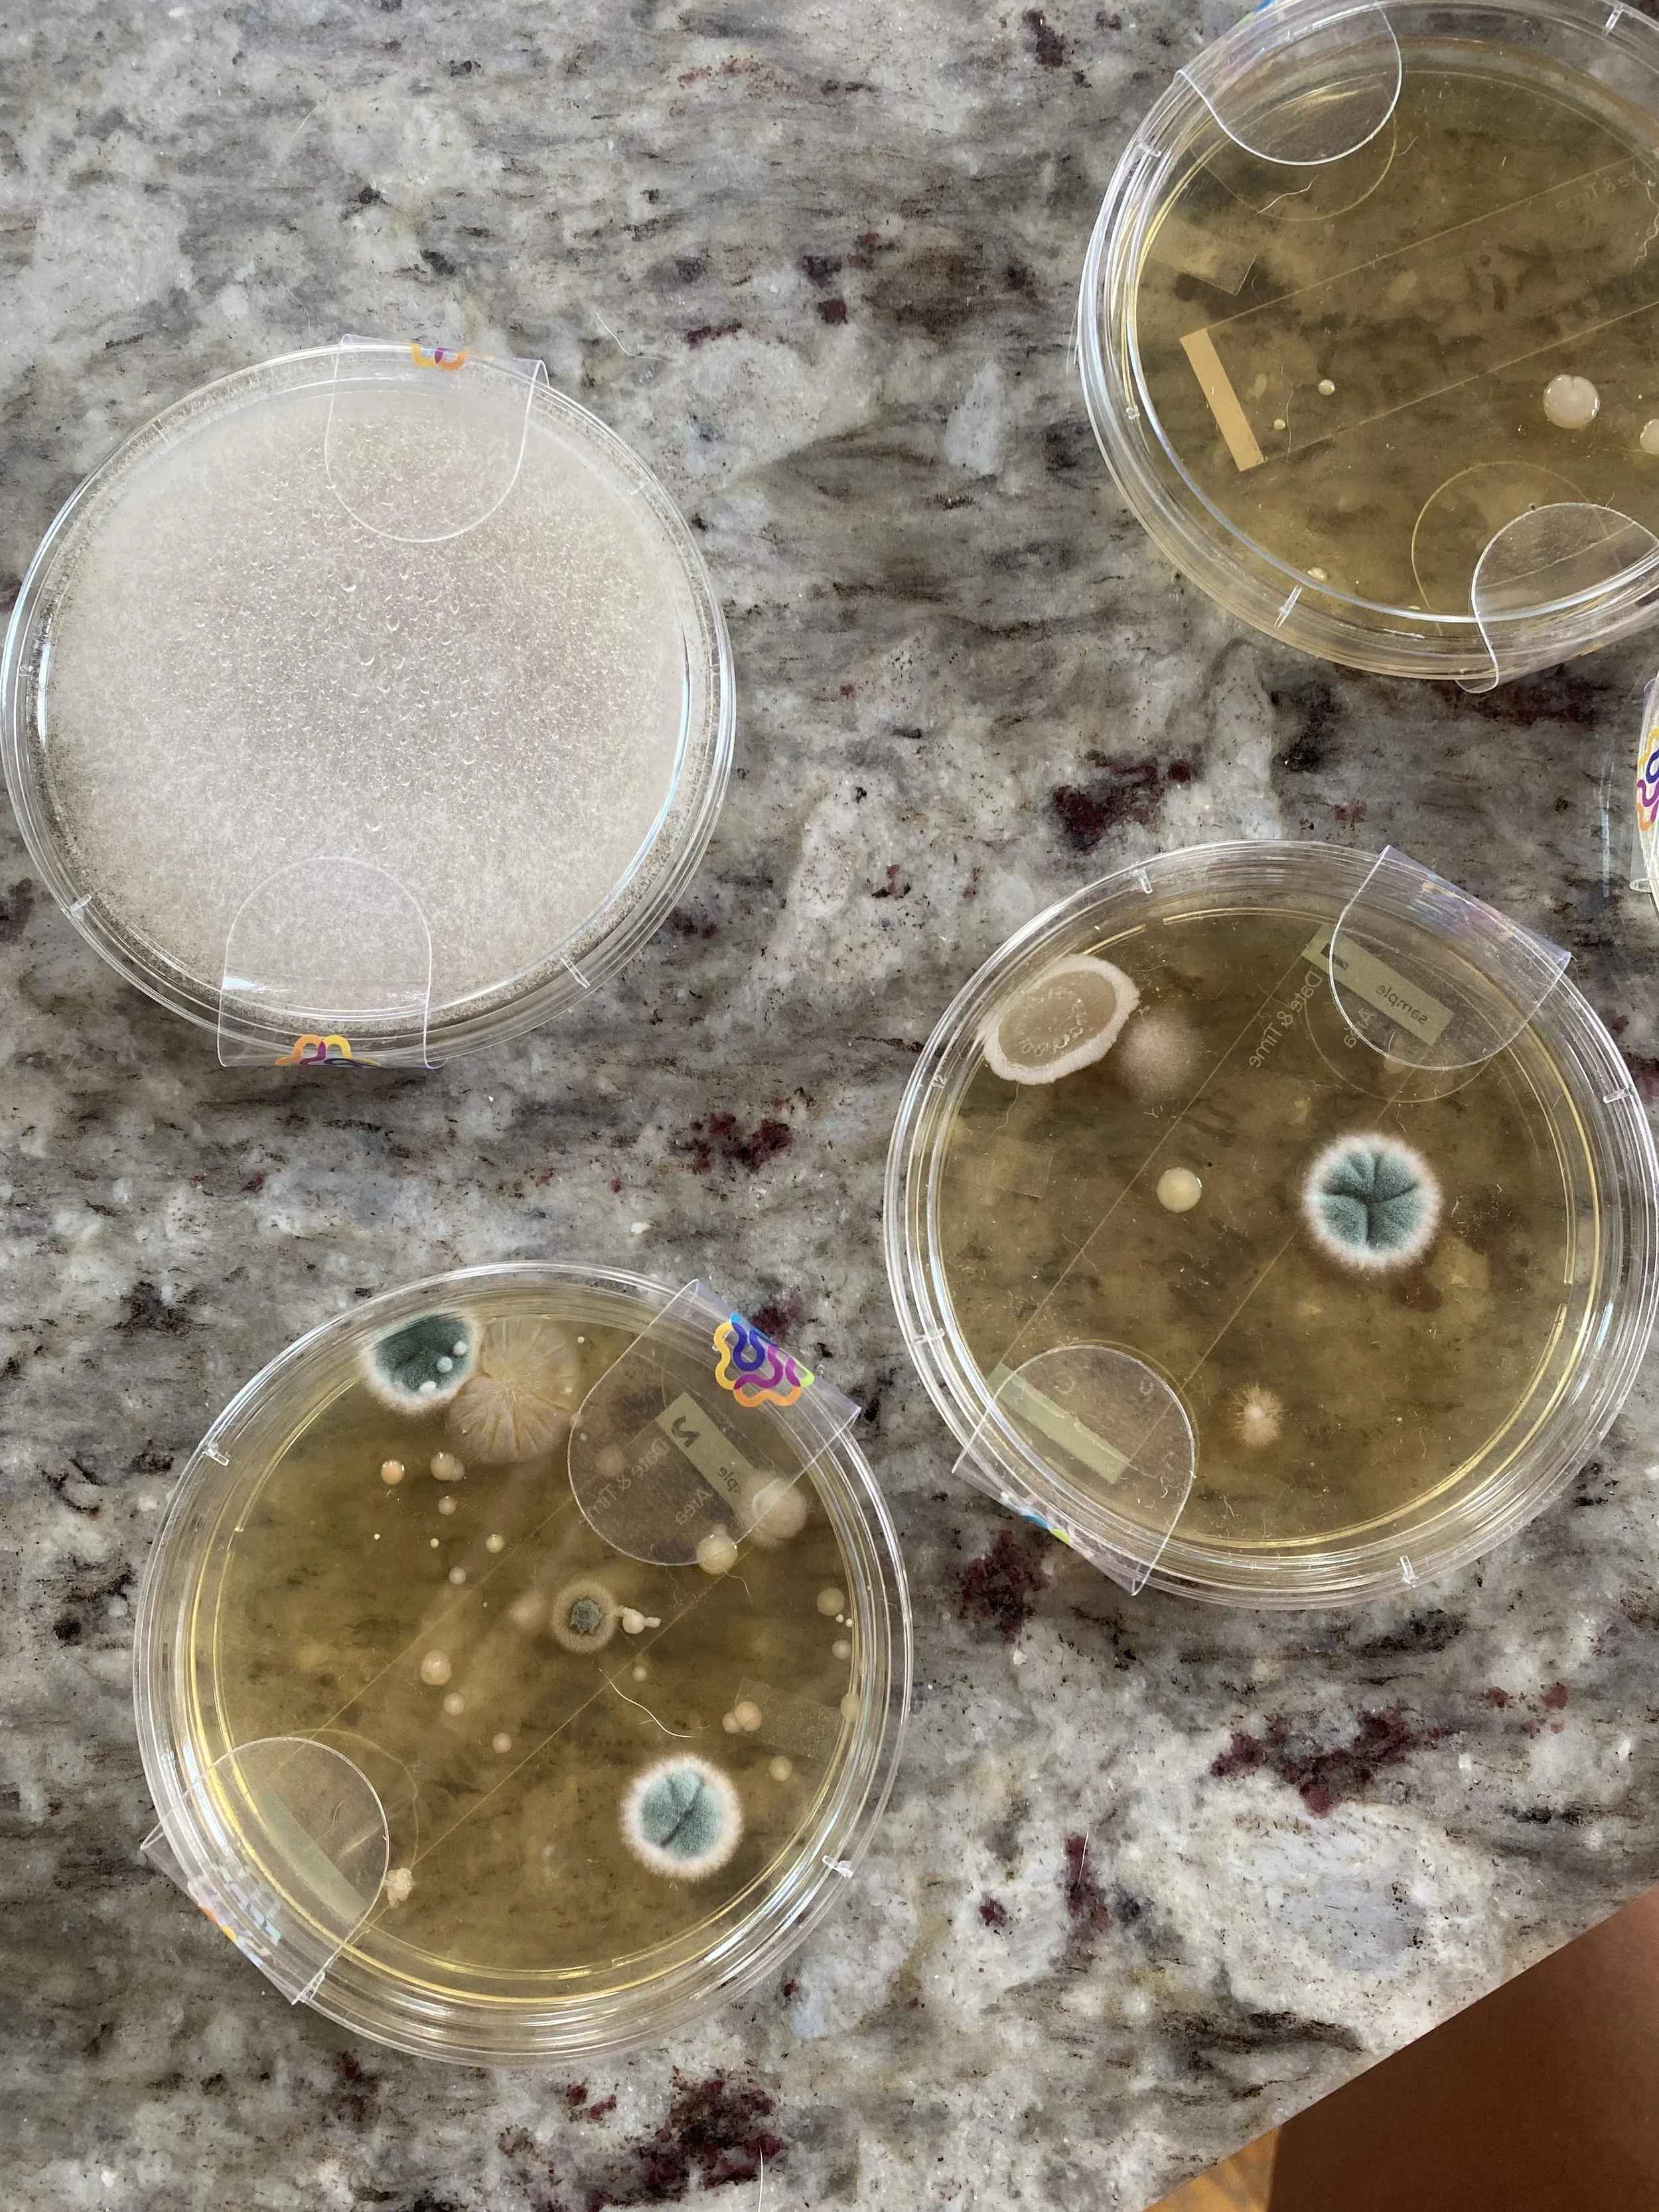

How Indie Lane Farm Came to be
From the outside of the social media bubble, it looks dreamy and life might look perfect. And this farm is dreamy. It's everything that we put on our vision board. It even looks a lot like the farmhouse that I drew for the vision board...which is CRAZY! (see pics) But getting here was not an easy road.
The Arizona rental that we loved.
In fall of 2022, we moved out of rental home in Arizona (that we loved) because of toxic mold levels. We were all so sick, and when we figured out what was going on, we left the home immediately and moved into an Airbnb. We lost so many of our belongings because of the risk of transferring toxic mold spores to another house. We were flat broke and struggling to pay our bills AGAIN. When we found out about the mold, we had just begun to recover from the extreme financial hardship we experienced when Jordan broke his back 2 years prior. Because of the mold, we paid thousands in testing for my health (I was the sickest out of all of us) and thousands more for mold testing of the home.
We weren't finding any rentals in Arizona that fit our needs or that looked safe (as far as mold goes) and we felt stuck. At that point, I had also been considering Wisconsin.
Wait. What?
Of all the places we had ever considered living, Wisconsin had never been on our radar. So how did we end up here?
In the fall of 2021, Jordan was traveling for a race. We all missed him terribly and Milo said out of the blue, "Let’s start a farm so that Dad can stay home and work and not have to travel." I pondered the idea for a moment and thought...ya know actually that's not a bad idea! We sat down with a yellow, lined pad of paper, and over the course of the next hour, I wrote down all the farm ideas that Theo and Milo rattled off. The next day we told Jordan the very extensive list of farm ideas. He loved it, although he certainly figured it was just some fun whim of an idea! We did have some experience with farming and ranching from our time of living in Oregon and the PNW. When we became vegan, the idea of ranching obviously became impossible, and we left that life behind us. We did build a large permaculture garden on our farm in Washington, but that's a whole other story.
We loved Arizona and the expansive views.
Over the course of a year, I was obsessively researching, planning, and skimming Arizona real estate to look for farm properties. We love Arizona and we have a great community of friends there. Moving away wasn't really an option, but as time went on I started to broaden my search of farm properties because Arizona didn't really have what we were looking for...water being one of them! During that time we left veganism, which completely changed the seriousness of the farm idea. I knew that if our family was going to eat meat again I wanted to be as close as possible to the process. I started a business plan, got chickens, and started a garden in the desert all while dealing with chronic and strange health problems. It's also important to share that during this time I started to question my spiritual beliefs. I was fully immersed in the "new age" way of thinking. I believed in God, but it was this really general, broad way of thinking. I'm not going to go into my testimonial right now of how I found God, butI should do that in another post series because it's such an important and beautiful part of this story.
But back to the farm...
I had this conviction to start praying for our farm.
I had faith that "our farm" was somewhere, and I released any restrictions to where it would be. One night before bed (we were still in the mold home), I told the boys that we should try to pray for our farm and for the location to be made known to us. We fell asleep, and the next morning I woke up to a text from a friend with a listing for a farm in Wisconsin. Over the course of the next few weeks, I continued to pray for guidance and continued to be pointed to Wisconsin. I had two different people tell me at two different moments about farmland in Wisconsin. Jordan thought I was totally insane and wrote it off. I mean...I don't blame him because the whole idea WAS NUTS. I'd grown up hearing about Wisconsin because my step-mom is from Michigan/Wisconsin and her family still lives there. I had always been invited to go visit, but the timing never worked out. To me, it was a vision of freezing, long winters, and there was NO WAY I was moving back to some place so cold. HA!
The first plate mold test we did. We confirmed the mold with with two other professional tests.
The crack in the wall where water was dripping down from a window and stachy was growing.
During this time we got confirmation that our rental home had stachybotrys mold and we moved out immediately. Broke, homeless, and completely terrified, Jordan and I were constantly fighting and trying to stay afloat while we searched for rentals in Arizona. One night after a rough day, I completely collapsed and fell on my knees. I started to pray in a way I never had. I sobbed and prayed out of desperation, and pain and I prayed for help and guidance. How were we here AGAIN in such a difficult situation? Hadn't we experienced enough hardship? Did we deserve this? It felt like punishment. It was one of the darkest nights of my life. The next morning I woke and opened up a magazine next to my bed. The magazine fell open to a story of a couple who owned a small farm in Wisconsin. It was at that moment that I decided to go visit. I reached out to the step-family that lived there and Milo and I flew out a few days later. We drove around a lot of the state, looked at properties, and spent time getting to know family.
Lake Michigan
When we got back to Arizona, I continued to look for rentals in the Phoenix Valley, but also started looking in Wisconsin. With the rental shortage across the country, we had a hard time finding anything that would work for our family. Add 3 dogs into the mix and it was near impossible. A rental popped up in Wisconsin and I don't know...I just felt like I should apply for it. It felt comforting to know that we had family in Wisconsin. I am an only child and Jordan's sister passed away before having children. I lost my mom 13 years ago and there are no cousins, aunts or uncles to be had. I wanted something different for our boys and this amazing family on my stepmom's side was in Wisconsin with welcoming open arms. We got approved that day for the Wisconsin rental and planned a move for a couple of weeks later.
The hardest part of this entire move was that we weren't in a financial position to move together as a family. Jordan had to stay behind in Arizona to finish up his work. I cried for 3 days as the boys and I drove cross country alone with 3 dogs and 3 chickens (yes we moved with our little chickens). It felt impossibly hard, but I just kept leaning into this message that God wanted us in Wisconsin and that it was all happening for a reason. On the road trip, every time I would start to doubt the decision to move, I'd see a sign for Wisconsin...a LITERAL sign or I'd turn on a podcast to hear that the person was from Wisconsin. It was crazy! Little did we know that Jordan would end up flying back and forth for 6 months before being able to move. It's been a really painful experience living apart and so hard on the boys, but we just kept putting one foot in front of the other. When I arrived in Wisconsin I only had the belongings that would fit in the van. The boys and I slept on the floor on mattresses for months. We acquired a used couch and some bed frames and used boxes and crates for chairs until we could afford to slowly furnish the house.
The rental in Wisconsin with what little belongings we had.
It's now late winter. At this point, we weren't looking for a farm. We were just trying to recover financially and to repair our credit. There were so many days when it was hard to get out of bed...where I questioned the decision to move. I questioned God. But I just had to keep going back to faith and trust in the process, knowing that our living situation was temporary. In February we went to Connecticut to visit Jordan's mom and talked about moving there to be close to her. Maybe that was where we were supposed to end up? At that point, we were both very open to whatever was meant to be, and I trusted God. On the road trip home, I prayed to God for guidance. A few moments later, a text message came through from a fellow homeschool mama in Wisconsin. She shared that a homeschool family she knew had decided to sell their 5-acre homestead in Black Creek, WI. They were looking for a family who would take over their homestead and love it as they did. As we drove home, I scrolled through the photos and read a description of a farm that seemed made for us. Every last detail was exactly what we were looking for. The sellers had even planted a variety of medicinal herbs! I reached out to the seller immediately, and we hopped on the phone to make plans to view the property.
A week later, we visited the property, and the sellers showed us around and shared with us everything that they had done on the homestead.
It was a literal dream come true, and they wanted US to take it over. US! Can you believe it?!
Of course, we weren't in the financial position to buy anything at that point. We had just started working with a credit company to help us repair the damage from when Jordan broke his back. But the sellers were willing to work with us, and over the course of 2 months, we worked out a plan for us to purchase the property from them as soon as we could get financed. We moved in the last week of April 2023.
Indie Lane Farm Garden 2023
So, that's the story of how our dream farm came to be. I'm sharing it to hopefully inspire others who feel like their dreams will never come true. I'm so incredibly grateful. We had to have faith in God, take the giant, scary leap, and take lots of intentional action, but it happened. This property has everything we've ever dreamed about, and I'm still in shock and awe. Never give up on what you want!
If you've followed me for a long time, you've seen the journey that we've been on. From homesteading to veganism, to so many moves, to going back to school and multiple businesses I've started (that have flopped), to all the learning and growth...we're here on my childhood dream farm and all that moving and learning and failure has brought us here and came together to help us move forward in this beautiful reality that God has created for us.